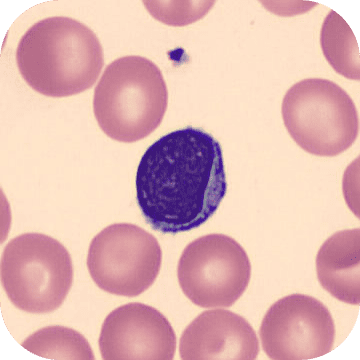
Lymphozyt

Übersicht
Die Leukozyten
- Lymphozyten (30%):
- B-Lymphozyten
- T-Lymphozyten
- Natürliche Killerzellen
- Granulozyten:
- Neutrophile Granulozyten (55-75%)
- Basophile Granulozyten (1%)
- Eosinophile Granulozyten (3%)
- Monozyten (6%)
- Mastzellen
- Dendritische Zellen
Die Leukozyten
TippMerksatz zur Leukozytenverteilung:
Never Let Monkeys Eat Bananas
- Neutrophile – ca. 60 %
- Lymphozyten – ca. 30 %
- Monozyten – ca. 6 %
- Eosinophile – ca. 3 %
- Basophile – ca. 1 %
Granulozyten
Granulozyten gehören zu den Leukozyten
Neutrophile Granulozyten:
- Allgemeines
- Häufigste Leukozytenart (ca. 40–60 %)
- Konzentration im Blut: 2.500–7.000/μl
- Verteilung:
- 90 % im Knochenmark
- 10 % im Blut (Verweildauer dort ca. 7 Stunden)
- Wenige im Gewebe
- Lebensdauer im Gewebe: 1–2 Tage
- Größe: ca. 12 μm
- Zytoplasma
: rosa gefärbt mit zahlreichen Granula
- Hauptfunktion: Schnelle Reaktion auf Bakterien; Phagozytose
und Zerstörung von Pathogenen - Morphologie
- Kern
- Segmentiert (3–5 Segmente), verbunden über dünne Brücken
- Stabkernige Granulozyten sind die vorletzte Reifestufe der Granulopoese
- Zellkern ist unsegmentiert bzw. S-förmig gekrümmt
- Anpassung der Kernform an Zellbewegung (z. B. bei Diapedese)
- Bei Frauen: „Drumstick“ bei manchen neutrophilen Granulozyten vorhanden → Inaktives X-Chromosom (Barr-Körperchen)
- Granula
- Primäre (azurophile) Granula
- Entsprechen Lysosomen
- Färbung: violett
- Inhalt: saure Hydrolasen (z. B. Phospholipase, Kathepsin G)
- Sekundäre (spezifische) Granula
- Keine Anfärbung mit sauren oder basischen Farbstoffen
- Inhalt: Enzyme (z. B. Lysozym
) → Zerstörung von Bakterienwänden
- Primäre (azurophile) Granula
- Kern
Eosinophile Granulozyten:
- Allgemeines
- Anteil an Leukozyten
: 3 % - Anzahl im Blut: 0 – 450 /μl
- Werte > 700/μl = Eosinophilie (z. B. bei Wurmerkrankungen)
- Größe: > 12 μm
- Lebensdauer im Gewebe: 8–12 Tage
- Anteil an Leukozyten
- Hauptfunktion: Bekämpfung von Parasiten und Beteiligung an allergischen Reaktionen
- Morphologie
- Kern
- Heterochromatinreich
- Zweigespalten (Brillenform)
- Granula
- Groß, eosinophil (rot gefärbt), lysosomenähnlich
- Enzymreich mit hohem Anteil an basischen Proteinen
- Hauptbestandteile:
- Major Basic Protein (MBP) → Abtöten von Parasiten
- Kern
Basophile Granulozyten:
- Allgemeines
- Anteil an Leukozyten
: ≤ 1 % - Anzahl im Blut: bis 200/μl
- Größe: < 12 μm
- Anteil an Leukozyten
- Funktion
- Freisetzung von Histamin und anderen Mediatoren, die bei Entzündungen und allergischen Reaktionen eine Rolle spielen
- Tragen IgE-Rezeptoren auf ihrer Oberfläche
- Nach Antigenbindung: Freisetzung von Histamin und Prostaglandinen
- Morphologie
- Kern
- Heterochromatinreich
- Meist rundlich oder zweigeteilt
- Im Blutausstrich häufig von Granula überlagert
- Granula
- Fein, unregelmäßig groß, blau gefärbt
- Enthalten unter anderem: Peroxidase. Histamin, Heparin
- Kern
Monozyten
Monozyten sind eine Art von weißen Blutzellen
- Allgemeines
- Größte Leukozyten
(Durchmesser: bis 20 μm) - Zellkern:
- Hell, exzentrisch gelegen
- Meist oval oder nierenförmig, oft eingebuchtet
- Zytoplasma
: - Feine azurophile Granula (entsprechen Lysosomen)
- Größte Leukozyten
- Zirkulation und Differenzierung
- Bildung im Knochenmark
- Verweilen nur kurz im Blut (ca. 1 Tag)
- Einwanderung in Gewebe
- Dort Umwandlung in verschiedene Makrophagenformen
- Meist langlebig
- Ausgeprägte Fähigkeit zur Phagozytose
- Mononukleäres Phagozytensystem (MPS)
- Monozyten und Makrophagen
bilden das mononukleäre Phagozytensystem - Zu den MPS-Zellen zählen:
- Gewebsmakrophagen (Histiozyten) im lockeren Bindegewebe
- Makrophagen
in lymphatischen Organen und im Knochenmark - Alveolarmakrophagen in der Lunge
- Peritonealmakrophagen im Bauchfell
- Pleuramakrophagen im Lungenfell
- Kupffer-Zellen in der Leber
- Hofbauer-Zellen in der Plazenta
- Osteoklasten im Knochen
- Mikroglia im ZNS
- Monozyten und Makrophagen
Lymphozyten
Die Lymphozyten werden hauptsächlich in zwei Haupttypen unterteilt: B- Lymphozyten (B-Zellen) und T-Lymphozyten (T-Zellen). Sie spielen eine zentrale Rolle in der spezifischen (erworbenen) Immunantwort.
- Allgemeines
- Nur ein kleiner Teil zirkuliert im Blut
- Hauptverteilung in:
- Lymphatischen Organen
- Knochenmark
- Bindegewebe
- Spezialisierte Zellen des Immunsystems
- Klassifikation nach Größe
- Kleine Lymphozyten
- Häufigste Form im Blut
- Runder, dunkler Zellkern
- Schmaler basophiler Zytoplasmasaum
- Größe: kaum größer als Erythrozyten
- Einheitliches Erscheinungsbild, aber funktionell unterschiedliche Zelltypen:
- T-Lymphozyten (überwiegend)
- B-Lymphozyten (seltener)
- Große Lymphozyten
- Mehr Zytoplasma
- Exzentrisch gelegener, oft eingedellter Zellkern
- Funktionelle Bedeutung z. B. bei aktivierten T-Zellen oder natürlichen Killerzellen (NK-Zellen
)
- Mehr Zytoplasma
- Kleine Lymphozyten
Lymphozyt (May-Grünwald-Giemsa-Färbung) umgeben von Erythrozyten und einem Thrombozyten :
OpenStax College, CC BY 3.0 <https://creativecommons.org/licenses/by/3.0>, via Wikimedia Commons-